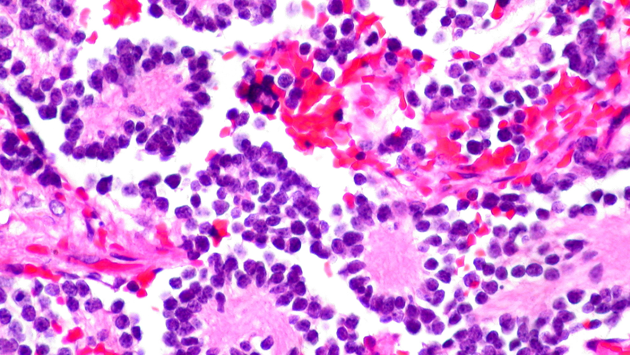
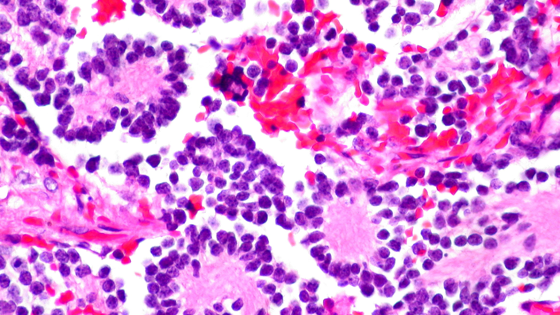

Подавление ферментов поможет вылечить нейробластому
Шведские ученые предложили лечить нейробластому — агрессивную форму детского рака, подавляя действие ферментов PRDX6 и GSTP1. Исследование на мышах показало, что такой способ лечения позволяет заменить раковые клетки у мышей на здоровые нервные клетки. Работа опубликована в журнале Proceedings of the National Academy of Sciences.Нейробластома — это онкологическое заболевание, поражающее симпатическую нервную систему, практически всегда — у детей. Это самый часто встречающийся рак у детей, в России от него страдает 1 ребенок из 100 тысяч. У некоторых пациентов прогноз лечения позитивный, а у других (очень часто у детей с метастазами) — негативный, несмотря на современные методики, комбинирующие хирургию, лучевую, химио- и иммунотерапию. А у тех, кому удалось выйти в ремиссию, часто до конца жизни остаются нарушенными когнитивные функции.Сейчас в лечении часто используется дифференциальная терапия, суть которой заключается в хирургическом лечении в сочетании с химиотерапией и, на поздних стадиях, пересадкой костного мозга. Однако не всегда это лечение помогает.Ученые из Швеции исследовали новый метод лечения нейробластомы с помощью подавления действия ферментов PRDX6 и GSTP1. Первый участвует в окислительно-восстановительной регуляции клетки, а второй — в метаболизме чужеродных веществ. Из-за того, что нейробластома вызывает окислительный стресс — повреждение клеток, связанное с усиленным проявлением активных форм кислорода и неспособностью организма восстанавливать причиненный вред, — количество ферментов PRDX6 и GSTP1 увеличивается. Обычно повышенный уровень PRDX6 и GSTP1 связан с худшим прогнозом лечения нейробластомы.Ученые провели эксперименты на клеточных культурах и в мышиных моделях, подавляя ферменты PRDX6 и GSTP1. В обоих случаях некоторые раковые клетки погибали, а вместо них созревали здоровые нейроны. Это останавливало рост опухоли.Теперь ученые планируют переходить к клиническим испытаниям нового метода.